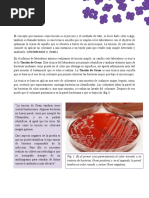

100% encontró este documento útil (1 voto)
360 vistas2 páginasDesaprender: Clave para el Cambio
El documento describe el concepto de desaprendizaje. Señala que desaprender no es olvidar, sino cuestionar la forma en que se aprende y encontrar nuevas formas de hacer las cosas. Explica que la formación para el desaprendizaje es fundamental para que las empresas y personas se actualicen. También detalla nueve pasos en el proceso de desaprendizaje, como reconocer lo que necesita cambiarse y desarrollar un nuevo enfoque a través de la práctica y el seguimiento.
Cargado por
pub mathDerechos de autor
© © All Rights Reserved
Nos tomamos en serio los derechos de los contenidos. Si sospechas que se trata de tu contenido, reclámalo aquí.
Formatos disponibles
Descarga como ODT, PDF, TXT o lee en línea desde Scribd
100% encontró este documento útil (1 voto)
360 vistas2 páginasDesaprender: Clave para el Cambio
El documento describe el concepto de desaprendizaje. Señala que desaprender no es olvidar, sino cuestionar la forma en que se aprende y encontrar nuevas formas de hacer las cosas. Explica que la formación para el desaprendizaje es fundamental para que las empresas y personas se actualicen. También detalla nueve pasos en el proceso de desaprendizaje, como reconocer lo que necesita cambiarse y desarrollar un nuevo enfoque a través de la práctica y el seguimiento.
Cargado por
pub mathDerechos de autor
© © All Rights Reserved
Nos tomamos en serio los derechos de los contenidos. Si sospechas que se trata de tu contenido, reclámalo aquí.
Formatos disponibles
Descarga como ODT, PDF, TXT o lee en línea desde Scribd